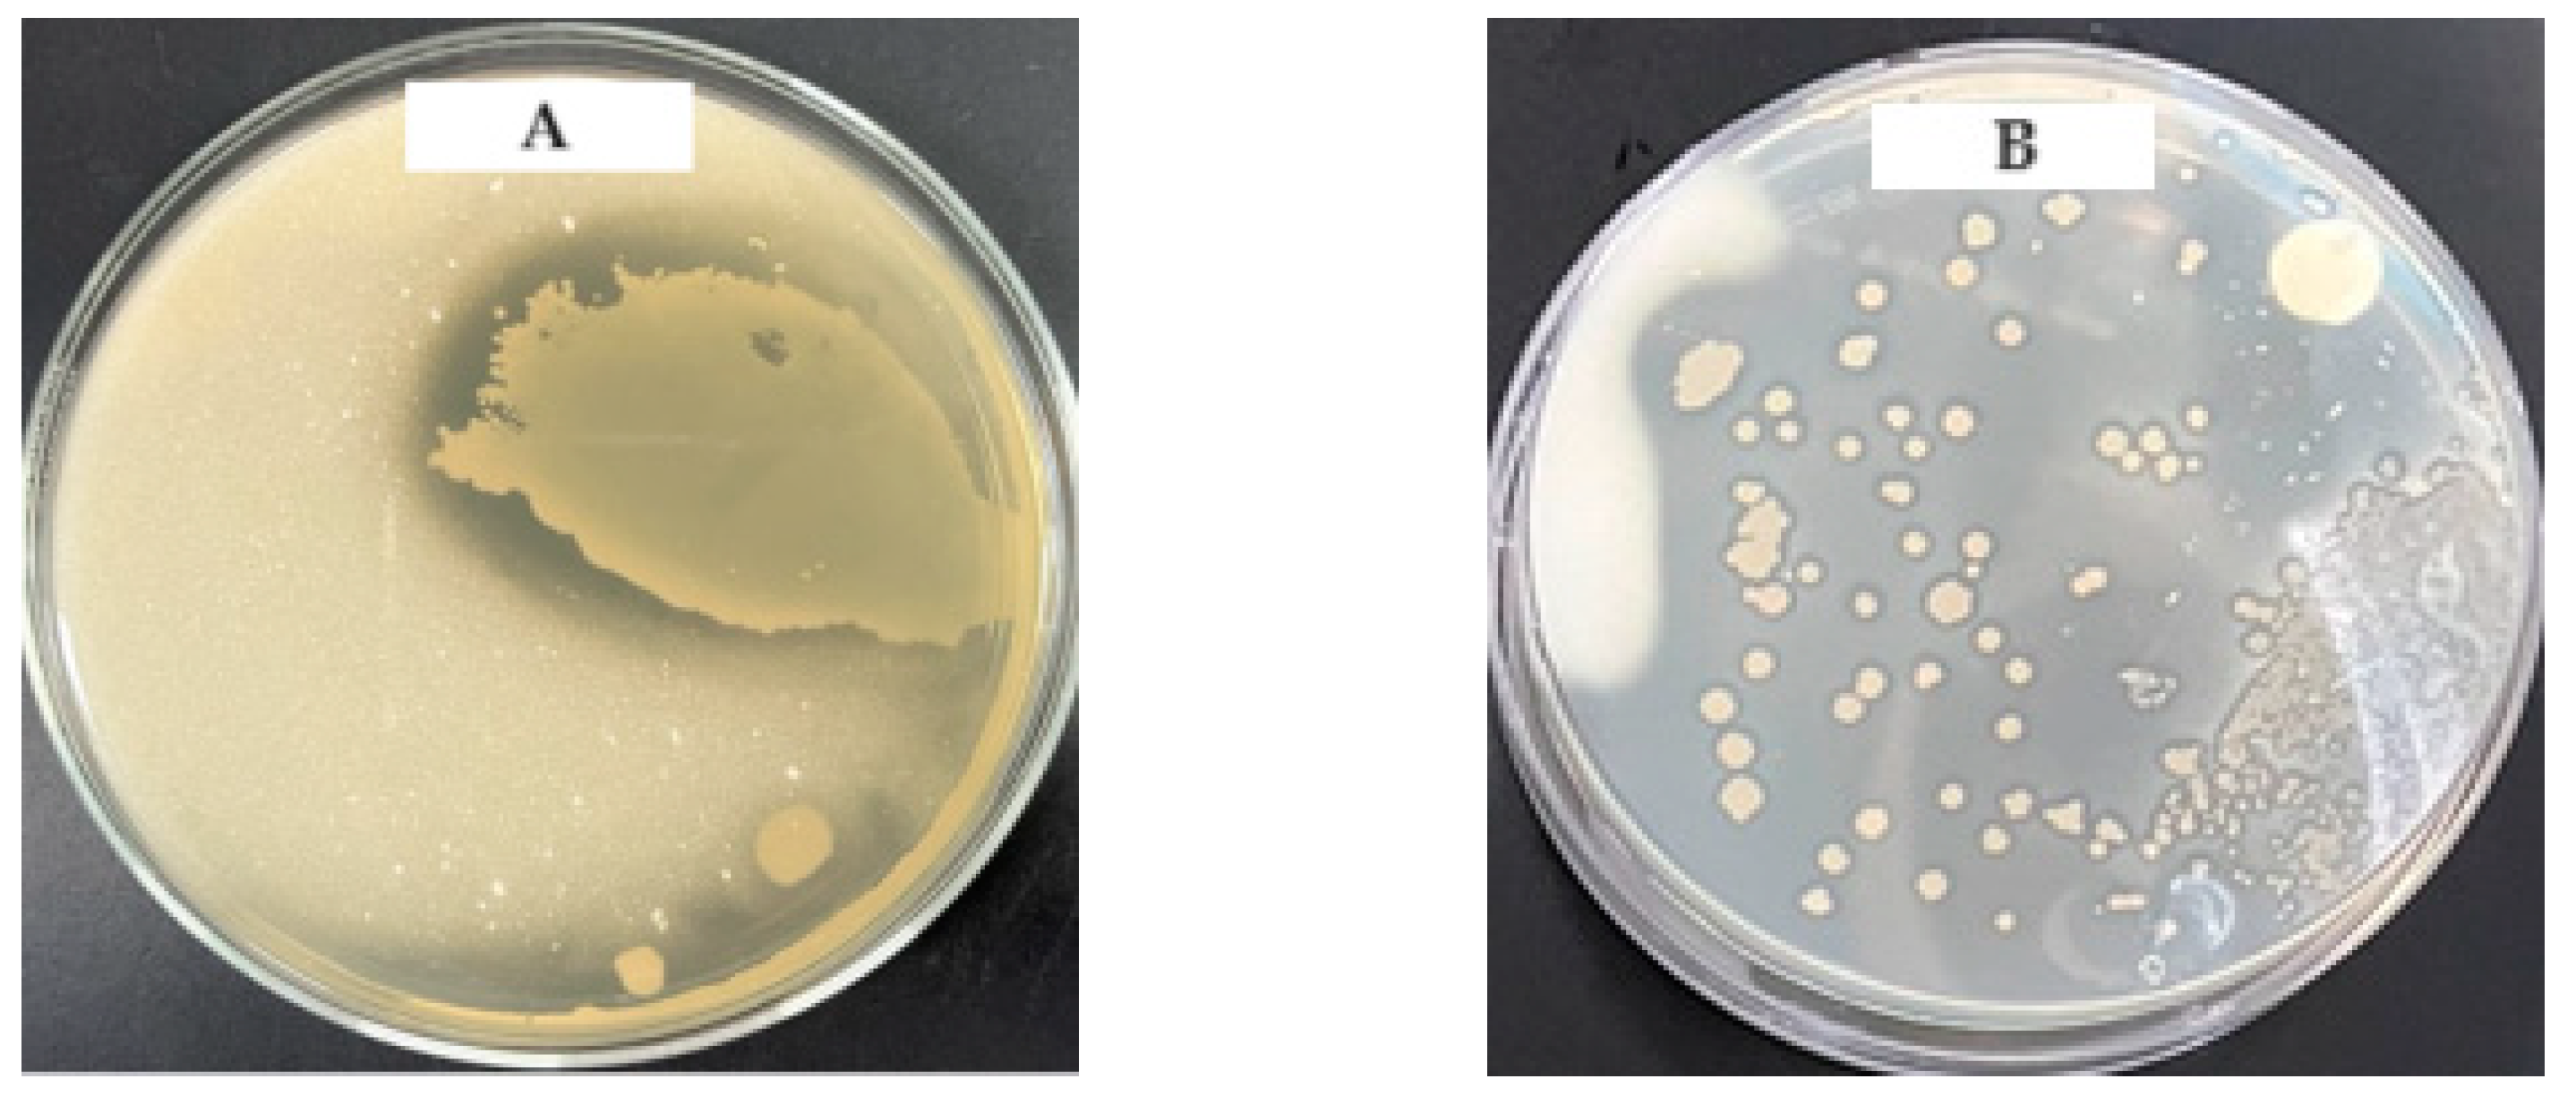
Fermentation 10 00018 g002 Fermentation 10 00018 g002

Screening of Acetic Acid Bacteria Isolated from Various Sources for Use in Kombucha Production
Abstract
1. Introduction
2. Materials and Methods
2.1. Materials
2.2. Reagents
2.3. Isolation, Screening, and Identification of the Most Suitable Strains of Acetic Acid Bacteria
2.3.1. Isolation of Acetic Acid Bacteria
2.3.2. Screening and Identification of Acetic ACID Bacteria
2.4. Selection of the Most Suitable Strains According to Fermentation Characteristics
2.4.1. Measurement of pH and Titratable Acidity (TTA)
2.4.2. Acid Resistance
2.4.3. Alcohol Tolerance
2.5. Viable Cell Count of Acetic Acid Bacteria
2.6. Content of Gluconate and Glucuronic Acid
2.7. Statistical Analysis
3. Results and Discussion
3.1. Isolation, Screening, and Identification of the Most Suitable Strains for Production of Acetic Acid and Gluconic Acid Bacteria for Kombucha Fermentation
3.1.1. Isolation and Selection of Acetic Acid Bacteria
3.1.2. Identification of Isolated Strains
3.2. Fermentation Characteristics of Selected Strains
3.2.1. Titratable Acidity (TTA)
3.2.2. Acid Resistance
3.2.3. Alcohol Tolerance
3.3. Fermentation Characteristics According to Fermentation Temperature and Time
3.3.1. pH, Titratable Acidity, and Viable Cell Count
3.3.2. Content of Gluconate and Glucuronic Acid
4. Conclusions
Author Contributions
Funding
Institutional Review Board Statement
Informed Consent Statement
Data Availability Statement
Conflicts of Interest
References
- Saichana, N.; Matsushita, K.; Adachi, O.; Frébort, I.; Frebortova, J. Acetic acid bacteria: A group of bacteria with versatile biotechnological applications. Biotechnol. Adv. 2015, 33, 1260–1271. [Google Scholar] [CrossRef] [PubMed]
- Qin, Z.; Yu, S.; Chen, J.; Zhou, J. Dehydrogenases of acetic acid bacteria. Biotechnol. Adv. 2022, 54, 107863. [Google Scholar] [CrossRef] [PubMed]
- Baek, S.Y.; Kim, J.S.; Mun, J.Y.; Lee, C.H.; Park, Y.K.; Yeo, S.H. Quality characteristics of detoxified Rhus verniciflua vinegar fermented using different acetic acid bacteria. Korean J. Food Preserv. 2016, 23, 347–354. [Google Scholar] [CrossRef]
- Gomes, R.J.; De Fatima Borges, M.; De Freitas Rosa, M.; Castro-Gómez, R.J.H.; Spinosa, W.A. Acetic acid bacteria in the food industry: Systematics, characteristics and applications. Food Technol. Biotechnol. 2018, 56, 139–151. [Google Scholar] [CrossRef] [PubMed]
- Deppenmeier, U.; Hoffmeister, M.; Prust, C. Biochemistry and biotechnological applications of Gluconobacter strains. Appl. Microbiol. Biotechnol. 2002, 60, 233–242. [Google Scholar] [CrossRef] [PubMed]
- Ministry of Food and Drug Safety. Food Code (No. 2023-13, 2023. 02. 17.). pp. 23–26. Available online: https://various.foodsafetykorea.go.kr/fsd/#/ (accessed on 6 March 2023).
- Yim, E.J.; Jo, S.W.; Lee, E.S.; Park, H.S.; Ryu, M.S.; Uhm, T.B.; Kim, H.Y.; Cho, S.H. Fermentation characteristics of mulberry (Cudrania tricuspidata) fruit vinegar produced by acetic acid bacteria isolated from traditional fermented foods. Korean J. Food Preserv. 2015, 22, 108–118. [Google Scholar] [CrossRef]
- Wang, B.; Rutherfurd-markwick, K.; Zhang, X.X.; Mutukumira, A.N. Kombucha: Production and microbiological research. Foods 2022, 11, 3456. [Google Scholar] [CrossRef]
- Villarreal-soto, S.A.; Beaufort, S.; Bouajila, J.; Souchard, J.P.; Taillandier, P. Understanding kombucha tea fermentation: A review. J. Food Sci. 2018, 83, 580–588. [Google Scholar] [CrossRef]
- Dufresne, C.; Farnworth, E. Tea, Kombucha, and health: A review. Food Res. Int. 2000, 33, 409–421. [Google Scholar] [CrossRef]
- Bishop, P.; Pitts, E.R.; Budner, D.; Thompson-witrick, K.A. Kombucha: Biochemical and microbiological impacts on the chemical and flavor profile. Food Chem. Adv. 2022, 1, 100025. [Google Scholar] [CrossRef]
- Soares, M.G.; Lima, M.D.; Schmidt, V.C.R. Technological aspects of kombucha, its applications and the symbiotic culture (SCOBY), and extraction of compounds of interest: A literature review. Trends Food Sci. Technol. 2021, 110, 539–550. [Google Scholar] [CrossRef]
- Jayabalan, R.; Malbaša, R.V.; Lončar, E.S.; Vitas, J.S.; Sathishkumar, M. A review on kombucha tea—Microbiology, composition, fermentation, beneficial effects, toxicity, and tea fungus. Compr. Rev. Food Sci. Food Saf. 2014, 13, 538–550. [Google Scholar] [CrossRef] [PubMed]
- Laavanya, D.; Shirkole, S.; Balasubramanian, P. Current challenges, applications and future perspectives of SCOBY cellulose of Kombucha fermentation. J. Clean. Prod. 2021, 295, 126454. [Google Scholar] [CrossRef]
- Malbaša, R.V.; Lončar, E.S.; Vitas, J.S.; Čanadanović-Brunet, J.M. Influence of starter cultures on the antioxidant activity of kombucha beverage. Food Chem. 2011, 127, 1727–1731. [Google Scholar] [CrossRef]
- Karabiyikli, S.; Sengun, I. Beneficial effects of acetic acid bacteria and their food products. In Acetic Acid Bacteria; CRC Press: Boca Raton, FL, USA, 2017; pp. 321–342. Available online: https://www.taylorfrancis.com/chapters/edit/10.1201/9781315153490-15/ (accessed on 10 November 2023).
- Villarreal-soto, S.A.; Bouajila, J.; Pace, M.; Leech, J.; Cotter, P.D.; Souchard, J.P.; Taillandier, P.; Beaufort, S. Metabolome-microbiome signatures in the fermented beverage, Kombucha. Int. J. Food Microbiol. 2020, 333, 108778. [Google Scholar] [CrossRef] [PubMed]
- Wang, B.; Rutherfurd-markwick, K.; Zhang, X.X.; Mutukumira, A.N. Isolation and characterisation of dominant acetic acid bacteria and yeast isolated from Kombucha samples at point of sale in New Zealand. Curr. Res. Food Sci. 2022, 5, 835–844. [Google Scholar] [CrossRef] [PubMed]
- Arifuzzaman, M.; Hasan, M.Z.; Rahman, S.M.B.; Pramanik, M.K. Isolation and characterization of Acetobacter and Gluconobacter spp from sugarcane and rotten fruits. Res. Rev. Biosci. 2014, 8, 359–365. [Google Scholar] [CrossRef]
- Hucker, G.J.; Conn, H.J. Methods of Gram Staining; Technical Bulletin of the New York State Agricultural Experiment Station: Ithaca, NY, USA, 1923; pp. 1–23. Available online: http://ecommons.library.cornell.edu/handle/1813/30787 (accessed on 6 March 2023).
- Karen, R. Catalase Test Protocol; American Society of Microbiology: Washington, DC, USA, 2010; pp. 1–9. Available online: https://asm.org/getattachment/72a871fc-ba92-4128-a194-6f1bab5c3ab7/Catalase-Test-Protocol.pdf (accessed on 6 March 2023).
- Wan, M.; Rosenberg, J.N.; Faruq, J.; Betenbaugh, M.J.; Xia, J. An improved colony PCR procedure for genetic screening of Chlorella and related microalgae. Biotechnol. Lett. 2011, 33, 1615–1619. [Google Scholar] [CrossRef]
- Saitou, N.; Nei, M. The neighbor-joining method: A new method for reconstructing phylogenetic trees. Mol. Biol. Evol. 1987, 4, 406–425. [Google Scholar] [CrossRef]
- Guangsen, T.; Xiang, L.; Jiahu, G. Microbial diversity and volatile metabolites of kefir prepared by different milk types. CYTA J. Food 2021, 19, 339–407. [Google Scholar] [CrossRef]
- Kim, M.J.; Kim, B.H.; Han, J.K.; Lee, S.Y.; Kim, K.S. Analysis of Quality Properties and Fermentative Microbial Profiles of Takju and Yakju Brewed with of without Steaming Process. J. Food Hyg. Saf. 2011, 26, 64–69. Available online: https://koreascience.kr/article/JAKO201117148817199.page (accessed on 6 March 2023).
- Lee, J.C.; Han, W.C.; Lee, J.H.; Jang, K.H. Quality Evaluation of Vinegar Manufactured using Rice and Rosa rugosa Thunb. Korean J. Food Sci. Technol. 2012, 44, 202–206. [Google Scholar] [CrossRef]
- Ansari, F.; Pourjafar, H.; Kangari, A.; Homayouni, A. Evaluation of the glucuronic acid production and antibacterial properties of kombucha black tea. Curr. Pharm. Biotechnol. 2019, 20, 985–990. [Google Scholar] [CrossRef] [PubMed]
- Adnan, A.F.M.; Tan, I.K.P. Isolation of lactic acid bacteria from Malaysian foods and assessment of the isolates for industrial potential. Bioresour. Technol. 2007, 98, 1380–1385. [Google Scholar] [CrossRef] [PubMed]
- Sengun, I.Y.; Karabiyikli, S. Importance of acetic acid bacteria in food industry. Food Control 2011, 22, 647–656. [Google Scholar] [CrossRef]
- Sandu, M.P.; Sidelnikov, V.S.; Geraskin, A.A.; Chernyavskii, A.V.; Kurzina, I.A. Influence of the method of preparation of the Pd-Bi/Al2O3 catalyst on catalytic properties in the reaction of liquid-phase oxidation of glucose into gluconic acid. Catalysts 2020, 10, 271. [Google Scholar] [CrossRef]
- Tomotani, E.J.; Das Neves, L.C.M.; Vitolo, M. Oxidation of glucose to gluconic acid by glucose oxidase in a membrane bioreactor. Appl. Biochem. Biotechnol. 2005, 121, 149–162. [Google Scholar] [CrossRef]
- Gupta, A.; Singh, V.K.; Qazi, G.N.; Kumar, A. Gluconobacter oxydans: Its biotechnological applications. J. Mol. Microbiol. Biotechnol. 2001, 3, 445–456. Available online: https://pubmed.ncbi.nlm.nih.gov/11361077/ (accessed on 6 March 2023).
- Moonmangmee, D.; Adachi, O.; Ano, Y.; Shinagawa, E.; Toyama, H.; Theeragool, G.; Lotong, N.; Matsushita, K. Isolation and characterization of thermotolerant Gluconobacter strains catalyzing oxidative fermentation at higher temperatures. Biosci. Biotechnol. Biochem. 2000, 64, 2306–2315. [Google Scholar] [CrossRef][Green Version]
- Eom, H.J.; Yoon, H.S.; Kwon, N.R.; Jeong, Y.J.; Kim, Y.H.; Hong, S.T.; Han, N.S. Comparison of the Quality Properties and Identification of Acetic Acid Bacteria for Aronia Vinegar. J. Korean Soc. Food Sci. Nutr. 2019, 48, 1397–1404. [Google Scholar] [CrossRef]
- Shafiei, R.; Delvigne, F.; Babanezhad, M.; Thonart, P. Evaluation of viability and growth of Acetobacter senegalensis under different stress conditions. Int. J. Food Microbiol. 2013, 163, 204–213. [Google Scholar] [CrossRef] [PubMed]
- Bang, K.H.; Kim, C.W.; Kim, C.H. Isolation of an Acetic Acid Bacterium Acetobacter pasteurianus CK-1 and Its Fermentation Characteristics. J. Life Sci. 2022, 32, 119–124. [Google Scholar] [CrossRef]
- Park, K.S.; Chang, D.S.; Cho, H.R.; Park, U.Y. Investigation of the Cultural Characteristics of High Concentration. J. Korean Soc. Food Sci. Nutr. 1994, 23, 666–670. Available online: https://koreascience.kr/article/JAKO199411920151954.page (accessed on 6 March 2023).
- Sim, K.C.; Lee, K.S.; Kim, D.H.; Ryu, I.H.; Lee, J.S. Studies on the Acid Tolerance of Acetobacter sp. Isolated from Persimmon Vinegar. Korean J. Food Sci. Technol. 2001, 33, 574–581. Available online: https://koreascience.kr/article/JAKO200103042136245.page (accessed on 6 March 2023).
- El-askri, T.; Yatim, M.; Sehli, Y.; Rahou, A.; Belhaj, A.; Castro, R.; Duran-guerrero, E.; Hafidi, M.; Zouhair, R. Screening and characterization of new Acetobacter fabarum and Acetobacter pasteurianus strains with high ethanol–thermo tolerance and the optimization of acetic acid production. Microorganisms 2022, 10, 1741. [Google Scholar] [CrossRef] [PubMed]
- Kim, Y.D.; Kang, S.K.; Kang, S.H. Studies on the acetic acid fermentation using maesil juice. J. Korean Soc. Food Sci. Nutr. 1996, 25, 695–700. Available online: https://koreascience.kr/article/JAKO199611921348361.page (accessed on 6 March 2023).
- Es-sbata, I.; Lakhlifi, T.; Yatim, M.; El-abid, H.; Belhaj, A.; Hafidi, M.; Zouhair, R. Screening and molecular characterization of new thermo- and ethanol-tolerant Acetobacter malorum strains isolated from two biomes Moroccan cactus fruits. Biotechnol. Appl. Biochem. 2021, 68, 476–485. [Google Scholar] [CrossRef]
- Antolak, H.; Piechota, D.; Kucharska, A. Kombucha tea—A double power of bioactive compounds from tea and symbiotic culture of bacteria and yeasts(SCOBY). Antioxidants 2021, 10, 1541. [Google Scholar] [CrossRef]
- Filippis, F.D.; Troise, A.D.; Vitaglione, P.; Ercolini, D. Different temperatures select distinctive acetic acid bacteria species and promotes organic acids production during Kombucha tea fermentation. Food Microbiol. 2018, 73, 11–16. [Google Scholar] [CrossRef]
- Magalhaes, K.T.; Pereira, G.V.; Dias, D.R.; Schwan, R.F. Microbial communities and chemical changes during fermentation of sugary Brazilian kefir. World J. Microbiol. Biotechnol. 2010, 26, 1241–1250. [Google Scholar] [CrossRef]
- Gullo, M.; Verzelloni, E.; Canonico, M. Aerobic submerged fermentation by acetic acid bacteria for vinegar production: Process and biotechnological aspects. Process Biochem. 2014, 49, 1571–1579. [Google Scholar] [CrossRef]
- Sharafi, S.M.; Rasooli, I.; Beheshti-maaI, K. Isolation characterization and optimization of indigenous acetic acid bacteria and evaluation of their preservation methods. Iran. J. Microbiol. 2010, 2, 38–45. Available online: https://pubmed.ncbi.nlm.nih.gov/22347549/ (accessed on 6 March 2023). [PubMed]
- Vīna, I.; Linde, R.; Patetko, A.; Semjonovs, P. Glucuronic acid containing fermented functional beverages produced by natural yeasts and bacteria associations. Int. J. Res. Rev. Appl. 2013, 14, 17–25. Available online: https://research.kombuchabrewers.org/wp-content/uploads/kk-research-files/glucuronic-acid-containing-fermented-functional-beverages-produced-by-natural-yeasts-and-bacteria-as.pdf (accessed on 10 November 2023).
- Merchie, G.; Lavens, P.; Sorgeloos, P. Optimization of dietary vitamin C in fish and crustacean larvae: A review. Aquaculture 1997, 155, 165–181. [Google Scholar] [CrossRef]
- Dai, L.; Lian, Z.; Zhang, R.; Nawaz, A.; Ul-haq, I.; Zhou, X.; Xu, Y. Multi-strategy in production of high titer gluconic acid by the fermentation of concentrated cellulosic hydrolysate with Gluconobacter oxydans. Ind. Crops Prod. 2022, 189, 115748. [Google Scholar] [CrossRef]
- Lee, H.C.; Chung, B.W.; Kim, C.Y.; Kim, D.H.; Ra, B.K. The production of sodium gluconate by Aspergillus niger. Korean J. Biotechnol. Bioeng. 1996, 11, 65–70. Available online: https://koreascience.kr/article/JAKO199611919973454.page (accessed on 6 March 2023).
- Jayabalan, R.; Marimuthu, S.; Swaminathan, K. Changes in content of organic acids and tea polyphenols during kombucha tea fermentation. Food Chem. 2007, 102, 392–398. [Google Scholar] [CrossRef]
- Chen, C.; Liu, B.Y. Changes in major components of tea fungus metabolites during prolonged fermentation. J. Appl. Microbiol. 2000, 89, 834–839. [Google Scholar] [CrossRef]
- Wu, X.; Yao, H.; Liu, Q.; Zheng, Z.; Cao, L.; Mu, D.; Wang, H.; Jiang, S.; Li, X. Producing acetic acid of Acetobacter pasteurianus by fermentation characteristics and metabolic flux analysis. Appl. Biochem. Biotechnol. 2018, 186, 217–232. [Google Scholar] [CrossRef]
- Nie, W.; Zheng, X.; Feng, W.; Liu, Y.; Li, Y.; Liang, X. Characterization of bacterial cellulose produced by Acetobacter pasteurianus MGC-N8819 utilizing lotus rhizome. LWT 2022, 165, 113763. [Google Scholar] [CrossRef]
- Da silva, G.A.R.; Oliveira, S.S.D.; Lima, S.F.; Nascimento, R.P.; Baptista, A.R.D.; Fiaux, S.B. The industrial versatility of Gluconobacter oxydans: Current applications and future perspectives. World J. Microbiol. Biotechnol. 2022, 38, 134. [Google Scholar] [CrossRef] [PubMed]
- Ko, H.M.; Shin, S.S.; Park, S.S. Biological activities of kombucha by stater culture fermentation with Gluconacetobacter spp. J. Korean Soc. Food Sci. Nutr. 2017, 46, 896–902. [Google Scholar] [CrossRef]
- Sknepnek, A.; Tomic, S.; Miletic, D.; Levic, S.; Colic, M.; Nedovic, V.; Niksic, M. Fermentation characteristics of novel Coriolus versicolor and Lentinus edodes kombucha beverages and immunomodulatory potential of their polysaccharide extracts. Food Chem. 2021, 342, 128344. [Google Scholar] [CrossRef] [PubMed]
- Tran, T.; Grandvalet, C.; Verdier, F.; Martin, A.; Alexandre, H.; Tourdot-marechal, R.T. Microbiological and technological parameters impacting the chemical composition and sensory quality of kombucha. Compr. Rev. Food Sci. Food Saf. 2020, 19, 2050–2070. [Google Scholar] [CrossRef]
- Wang, S.; Zhang, L.; Qi, L.; Liang, H.; Lin, X.; Li, S.; Yu, C.; Ji, C. Effect of synthetic microbial community on nutraceutical and sensory qualities of kombucha. Int. J. Food Sci. Technol. 2020, 55, 3327–3333. [Google Scholar] [CrossRef]

| Isolate | Morphological | Biological | D-Mannitol Assimilation | |||
|---|---|---|---|---|---|---|
| Colony Morphology | Gram Staining | Gluconic Acid Test | Biofilm Formation | Catalase Test | ||
| SVC-04 | rod-shaped, light brown | − | − | + | + | + |
| SVC-12 | rod-shaped, light brown | − | − | + | + | + |
| SVC-14 | rod-shaped, light brown | − | − | + | + | + |
| SVC-22 | rod-shaped, light brown | − | − | + | + | + |
| SVC-38 | rod-shaped, light brown | − | − | + | + | + |
| SVC-49 | rod-shaped, light brown | − | − | + | + | + |
| SVC-410 | rod-shaped, light brown | − | − | + | + | + |
| SVC-54 | rod-shaped, light brown | − | − | + | + | + |
| SMC-1 | rod-shaped, light brown | − | − | + | + | + |
| SMC-2 | rod-shaped, light brown | − | − | + | + | + |
| SMC-3 | rod-shaped, light brown | − | − | + | + | + |
| SMC-4 | rod-shaped, light brown | − | − | + | + | + |
| SMC-5 | rod-shaped, light brown | − | − | + | + | + |
| FPA-1 | rod-shaped, reddish brown | − | − | + | + | + |
| FPA-2 | rod-shaped, reddish brown | − | − | + | + | + |
| FPA-3 | rod-shaped, reddish brown | − | − | + | + | + |
| FPA-4 | Coccus, white | + | − | − | − | + |
| JGV-1 | rod-shaped, light brown | − | − | + | + | + |
| JGV-2 | rod-shaped, light brown | − | − | + | + | + |
| FPP-1 | Coccus, white | + | − | − | − | − |
| FPP-3 | Coccus, white | + | − | − | − | − |
| FPP-4 | Coccus, white | + | − | − | − | − |
| FPS-3 | Coccus, white | + | − | − | − | − |
| FPS-4 | rod-shaped, light brown | − | − | + | + | + |
| ACJ-1 | rod-shaped, light brown | − | − | + | + | + |
| ACJ-2 | rod-shaped, light brown | − | − | + | + | + |
| MPV-1 | rod-shaped, light brown | − | − | + | + | + |
| PVJ-1 | rod-shaped, light brown | − | − | + | + | + |
| PVJ-4 | rod-shaped, light brown | − | − | + | + | + |
| PVJ-5 | rod-shaped, light brown | − | − | + | + | + |
| VVJ-1 | rod-shaped, reddish brown | − | + | + | + | + |
| VVJ-2 | rod-shaped, reddish brown | − | + | + | + | + |
| AVJ-3 | rod-shaped, light brown | − | − | + | + | + |
| PEV-1 | rod-shaped, light brown | − | − | + | + | + |
| PEV-4 | rod-shaped, light brown | − | − | + | + | + |
| URV-1 | rod-shaped, light brown | − | − | + | + | + |
| URV-2 | rod-shaped, light brown | − | − | + | + | + |
| KS-1 | rod-shaped, light brown | − | − | + | + | + |
| KS-2 | rod-shaped, light brown | − | − | + | + | + |
| KS-3 | rod-shaped, light brown | − | − | + | + | + |
| PS-1 | rod-shaped, light brown | − | − | + | + | + |
| WS-1 | rod-shaped, light brown | − | − | + | + | + |
| Strains No. | Species | Identities (%) | Strain Distinction | Source |
|---|---|---|---|---|
| SVC-04 | Acetobacter pasteurianus 1 | 99.9 | SFT-1 | Vinegar, Sunchon University b3 115, Republic of Korea |
| SVC-12 | 99.7 | SFT-2 | ||
| SVC-14 | 99.7 | SFT-3 | ||
| SVC-22 | 99.9 | SFT-4 | ||
| SVC-38 | 99.9 | SFT-5 | ||
| SVC-49 | 99.9 | SFT-6 | ||
| SVC-410 | 99.8 | SFT-7 | ||
| SVC-54 | 99.5 | SFT-8 | ||
| FPA-1 | Acetobacter orientalis | 99.8 | SFT-9 | Prunus armeniaca (surface), Suncheon-si, Jeollanam-do, Republic of Korea |
| FPA-2 | 99.9 | SFT-10 | ||
| FPA-3 | 99.9 | SFT-11 | ||
| FPS-4 | Acetobacter cibinongensis | 99.6 | SFT-12 | Prunus salicina (surface), Suncheon-si, Jeollanam-do, Republic of Korea |
| JGV-1 | Acetobacter pasteurianus 1 | 99.8 | SFT-13 | Vinegar (persimmon), Jangseong-gun, Jeollanam-do, Republic of Korea |
| JGV-2 | 99.6 | SFT-14 | ||
| SMC-1 | Acetobacter pasteurianus 1 | 99.7 | SFT-15 | Maesil cheong, Sunchon University b3 115, Republic of Korea |
| SMC-2 | 99.5 | SFT-16 | ||
| SMC-3 | 99.8 | SFT-17 | ||
| SMC-4 | 99.6 | SFT-18 | ||
| SMC-5 | 99.7 | SFT-19 | ||
| ACJ-1 | Acetobacter pomorum | 99.4 | SFT-20 | Vinegar (Ananas comosus), Jangseong-gun, Jeollanam-do, Republic of Korea |
| ACJ-2 | 99.7 | SFT-21 | ||
| MPV-1 | Acetobacter pomorum | 99.5 | SFT-22 | Vinegar (Malus pumila), Jangseong-gun, Jeollanam-do, Republic of Korea |
| PVJ-1 | Acetobacter pomorum | 99.7 | SFT-23 | Vinegar (persimmon), Jangseong-gun, Jeollanam-do, Republic of Korea |
| PVJ-4 | 99.7 | SFT-24 | ||
| PVJ-5 | Acetobacter pasteurianus 1 | 99.8 | SFT-25 | |
| VVJ-1 | Gluconobacter oxydans 1 | 99.7 | SFT-26 | Vinegar (Vitis vinifera L.), Jangseong-gun, Jeollanam-do, Republic of Korea |
| VVJ-2 | 99.9 | SFT-27 | ||
| AVJ-3 | Acetobacter pomorum | 99.5 | SFT-28 | Vinegar (Aronia melanocarpa), Jangseong-gun, Jeollanam-do, Republic of Korea |
| PEV-1 | Acetobacter ascendens 1 | 99.9 | SFT-29 | Vinegar (Passiflora edulis), Jangseong-gun, Jeollanam-do, Republic of Korea |
| PEV-4 | 99.9 | SFT-30 | ||
| URV-1 | Acetobacter ascendens 1 | 99.9 | SFT-31 | Vinegar (Brown rice), Namwon-si, Jeollabuk-do, Republic of Korea |
| URV-2 | Acetobacter pomorum | 99.7 | SFT-32 | |
| KS-1 | Acetobacter pomorum | 99.8 | SFT-33 | Kombucha (Masontops), North York, ON, Canada |
| KS-2 | 99.9 | SFT-34 | ||
| KS-3 | 99.9 | SFT-35 | ||
| PS-1 | Acetobacter pomorum | 99.8 | SFT-36 | Peach cheong, Sunchon University b3 115, Republic of Korea |
| WS-1 | Acetobacter pomorum | 99.9 | SFT-37 | Wine, Sunchon University b3 115, Republic of Korea |
| Sample | Titratable Acidity (%) | |||
|---|---|---|---|---|
| Fermentation Time (Days) | ||||
| 0 | 1 | 2 | 3 | |
| Acetobacter pasteurianus (SFT-1) | 0.11 ± 0.00 1,ns | 0.27 ± 0.00 b | 0.64 ± 0.03 d | 1.18 ± 0.00 d |
| Acetobacter pasteurianus (SFT-2) | 0.22 ± 0.00 ef | 0.42 ± 0.02 hij | 0.75 ± 0.00 hi | |
| Acetobacter pasteurianus (SFT-3) | 0.24 ± 0.00 c | 0.49 ± 0.00 f | 0.87 ± 0.01 f | |
| Acetobacter pasteurianus (SFT-4) | 0.19 ± 0.01 hi | 0.36 ± 0.00 lmno | 0.55 ± 0.00 no | |
| Acetobacter pasteurianus (SFT-5) | 0.25 ± 0.01 c | 0.45 ± 0.05 gh | 0.85 ± 0.03 f | |
| Acetobacter pasteurianus (SFT-6) | 0.21 ± 0.01 fg | 0.60 ± 0.01 e | 1.07 ± 0.05 e | |
| Acetobacter pasteurianus (SFT-7) | 0.25 ± 0.00 c | 0.73 ± 0.01 b | 1.39 ± 0.01 b | |
| Acetobacter pasteurianus (SFT-8) | 0.23 ± 0.01 de | 0.48 ± 0.02 fg | 0.82 ± 0.03 fg | |
| Acetobacter orientalis (SFT-10) | 0.28 ± 0.02 ab | 0.84 ± 0.02 a | 1.48 ± 0.05 a | |
| Acetobacter cibinongensis (SFT-12) | 0.21 ± 0.00 fg | 0.34 ± 0.01 nop | 0.60 ± 0.02 lmn | |
| Acetobacter pasteurianus (SFT-13) | 0.21 ± 0.01 fg | 0.29 ± 0.00 opq | 0.45 ± 0.03 q | |
| Acetobacter pasteurianus (SFT-14) | 0.21 ± 0.00 fg | 0.28 ± 0.01 r | 0.38 ± 0.01 r | |
| Acetobacter pasteurianus (SFT-15) | 0.13 ± 0.01 k | 0.32 ± 0.01 pq | 0.70 ± 0.03 ijk | |
| Acetobacter pasteurianus (SFT-16) | 0.29 ± 0.02 a | 0.70 ± 0.02 bc | 1.28 ± 0.02 c | |
| Acetobacter pasteurianus (SFT-17) | 0.24 ± 0.02 c | 0.37 ± 0.02 lmn | 0.59 ± 0.06 mno | |
| Acetobacter pasteurianus (SFT-18) | 0.14 ± 0.00 jk | 0.27 ± 0.02 r | 0.72 ± 0.06 ij | |
| Acetobacter pasteurianus (SFT-19) | 0.22 ± 0.00 ef | 0.36 ± 0.01 lmno | 0.57 ± 0.01 mno | |
| Acetobacter pomorum (SFT-21) | 0.18 ± 0.00 i | 0.30 ± 0.00 qr | 0.54 ± 0.01 op | |
| Acetobacter pomorum (SFT-22) | 0.21 ± 0.00 fg | 0.34 ± 0.00 nop | 0.54 ± 0.03 op | |
| Acetobacter pomorum (SFT-24) | 0.22 ± 0.00 ef | 0.43 ± 0.02 hi | 0.75 ± 0.06 hi | |
| Acetobacter pasteurianus (SFT-25) | 0.20 ± 0.00 gh | 0.38 ± 0.01 klm | 0.68 ± 0.03 jk | |
| Gluconobacter oxydans (SFT-26) | 0.15 ± 0.01 j | 0.20 ± 0.02 s | 0.45 ± 0.01 q | |
| Gluconobacter oxydans (SFT-27) | 0.14 ± 0.00 jk | 0.21 ± 0.00 s | 0.47 ± 0.02 q | |
| Acetobacter pomorum (SFT-28) | 0.22 ± 0.00 ef | 0.39 ± 0.01 jkl | 0.65 ± 0.01 kl | |
| Acetobacter ascendens (SFT-29) | 0.23 ± 0.01 de | 0.41 ± 0.01 ijk | 0.73 ± 0.01 hij | |
| Acetobacter ascendens (SFT-30) | 0.27 ± 0.01 b | 0.69 ± 0.01 c | 1.36 ± 0.01 b | |
| Acetobacter ascendens (SFT-31) | 0.13 ± 0.01 k | 0.35 ± 0.02 mnop | 0.62 ± 0.01 lm | |
| Acetobacter pomorum (SFT-32) | 0.14 ± 0.00 jk | 0.37 ± 0.01 lmn | 0.70 ± 0.01 ijk | |
| Acetobacter malorum (SFT-33) | 0.25 ± 0.01 c | 0.43 ± 0.03 hi | 0.69 ± 0.01 jk | |
| Acetobacter malorum (SFT-36) | 0.27 ± 0.00 b | 0.51 ± 0.00 f | 0.78 ± 0.04 gh | |
| Acetobacter malorum (SFT-37) | 0.24 ± 0.01 cde | 0.33 ± 0.00 opq | 0.49 ± 0.04 pq | |
| Treatment | Acid Resistance (%) | Ethanol Tolerance (%) | |||||||||
|---|---|---|---|---|---|---|---|---|---|---|---|
| pH | Alcohol Content (%) | ||||||||||
| Sample | 4.0 | 5.0 | 6.0 | 7.0 | 8.0 | 2.0 | 4.0 | 6.0 | 8.0 | 10.0 | |
| Acetobacter pasteurianus (SFT-1) | 90.80 ± 0.08 1,d | 112.89 ± 0.16 a | 98.33 ± 0.09 c | 100.13 ± 0.09 b | 84.26 ± 0.06 e | 95.64 ± 0.07 a | 86.92 ± 0.14 e | 94.45 ± 0.07 b | 88.45 ± 0.21 c | 87.97 ± 0.07 d | |
| Acetobacter pasteurianus (SFT-2) | 80.73 ± 0.09 c | 99.60 ± 0.08 b | 73.57 ± 0.03 d | 101.99 ± 0.00 a | 61.46 ± 0.09 e | 108.78 ± 0.23 d | 126.33 ± 0.46 b | 129.33 ± 0.12 a | 123.21 ± 0.23 c | 122.75 ± 0.46 c | |
| Acetobacter pasteurianus (SFT-3) | 119.84 ± 0.23 b | 132.10 ± 0.11 a | 91.19 ± 0.11 e | 100.66 ± 0.11 c | 97.10 ± 0.12 d | 92.76 ± 0.07 a | 78.27 ± 0.00 d | 76.56 ± 0.32 e | 80.61 ± 0.26 c | 81.37 ± 0.19 b | |
| Acetobacter pasteurianus (SFT-4) | 100.63 ± 0.19 b | 118.18 ± 0.019 a | 95.43 ± 0.10 c | 100.34 ± 0.29 b | 87.13 ± 0.29 d | 97.09 ± 0.08 a | 91.26 ± 0.14 b | 80.31 ± 0.22 c | 77.11 ± 0.08 d | 67.52 ± 0.36 e | |
| Acetobacter pasteurianus (SFT-5) | 97.54 ± 0.10 c | 128.84 ± 0.10 a | 96.46 ± 0.20 d | 100.27 ± 0.10 b | 82.12 ± 0.10 e | 94.22 ± 0.13 a | 82.66 ± 0.26 b | 77.04 ± 0.13 c | 74.99 ± 0.26 d | 71.16 ± 0.06 e | |
| Acetobacter pasteurianus (SFT-6) | 66.05 ± 0.16 e | 72.01 ± 0.16 d | 92.97 ± 0.16 b | 100.51 ± 0.16 a | 85.35 ± 0.24 c | 94.01 ± 0.00 a | 82.02 ± 0.20 b | 77.98 ± 0.07 c | 72.26 ± 0.21 d | 67.61 ± 0.27 e | |
| Acetobacter pasteurianus (SFT-7) | 111.67 ± 0.12 b | 136.56 ± 0.45 a | 102.82 ± 0.23 c | 99.79 ± 0.00 d | 81.51 ± 0.11 e | 88.07 ± 0.24 a | 64.22 ± 0.12 e | 80.16 ± 0.18 c | 74.17 ± 0.06 d | 83.07 ± 0.12 b | |
| Acetobacter pasteurianus (SFT-8) | 120.77 ± 0.32 a | 92.80 ± 0.11 d | 75.96 ± 0.11 e | 101.81 ± 0.11 b | 100.75 ± 0.21 a | 100.05 ± 0.28 a | 100.14 ± 0.09 a | 88.99 ± 0.18 d | 91.07 ± 0.46 b | 90.35 ± 0.09 c | |
| Acetobacter orientalis (SFT-10) | 111.49 ± 0.14 b | 96.01 ± 0.14 d | 89.90 ± 0.41 e | 100.76 ± 0.27 c | 114.75 ± 0.68 a | 97.64 ± 0.12 b | 92.92 ± 0.37 c | 79.25 ± 0.25 e | 85.71 ± 0.63 d | 169.44 ± 0.10 a | |
| Acetobacter cibinongensis (SFT-12) | 56.19 ± 0.25 d | 32.96 ± 0.25 e | 97.43 ± 0.00 b | 100.19 ± 0.33 a | 78.19 ± 0.08 c | 119.63 ± 0.33 c | 158.89 ± 0.11 a | 158.24 ± 0.33 a | 132.97 ± 0.65 b | 114.32 ± 0.22 d | |
| Acetobacter pasteurianus (SFT-13) | 115.76 ± 0.11 b | 144.67 ± 0.11 a | 107.28 ± 0.11 c | 99.45 ± 0.22 d | 98.80 ± 0.11 e | 99.37 ± 0.08 c | 98.11 ± 0.34 d | 96.94 ± 0.25 e | 102.89 ± 0.09 b | 106.33 ± 0.09 a | |
| Acetobacter pasteurianus (SFT-14) | 90.93 ± 0.09 c | 103.69 ± 0.34 a | 103.69 ± 0.17 a | 99.72 ± 0.09 b | 78.17 ± 0.17 d | 100.84 ± 0.09 d | 102.52 ± 0.28 c | 106.26 ± 0.19 b | 118.21 ± 0.10 a | 102.71 ± 0.47 c | |
| Acetobacter pasteurianus (SFT-15) | 92.04 ± 0.23 c | 107.68 ± 0.08 a | 82.95 ± 0.39 d | 101.28 ± 0.23 b | 81.41 ± 0.00 e | 103.47 ± 0.15 b | 110.41 ± 0.15 a | 100.27 ± 0.31 d | 102.10 ± 0.31 c | 96.30 ± 0.08 e | |
| Acetobacter pasteurianus (SFT-16) | 108.33 ± 0.10 b | 117.40 ± 0.30 a | 101.78 ± 0.10 c | 99.87 ± 0.10 d | 80.62 ± 0.10 e | 86.79 ± 0.05 a | 60.37 ± 0.11 b | 60.48 ± 0.22 b | 59.94 ± 0.06 c | 55.82 ± 0.22 d | |
| Acetobacter pasteurianus (SFT-17) | 98.79 ± 0.21 d | 130.46 ± 0.21 a | 94.28 ± 0.10 e | 100.43 ± 0.10 c | 124.21 ± 0.21 b | 101.76 ± 0.08 c | 105.27 ± 0.24 a | 91.37 ± 0.08 e | 93.53 ± 0.24 d | 102.56 ± 0.08 b | |
| Acetobacter pasteurianus (SFT-18) | 114.56 ± 0.11 b | 120.88 ± 0.11 a | 97.88 ± 0.21 d | 100.16 ± 0.00 c | 86.07 ± 0.11 e | 94.82 ± 0.07 a | 84.46 ± 0.27 c | 79.41 ± 0.07 d | 92.16 ± 0.14 b | 55.76 ± 0.07 e | |
| Acetobacter pasteurianus (SFT-19) | 108.94 ± 0.10 b | 119.27 ± 0.20 a | 100.18 ± 0.10 c | 99.99 ± 0.20 c | 83.85 ± 0.59 d | 93.66 ± 0.13 a | 80.98 ± 0.06 b | 74.14 ± 0.13 c | 72.00 ± 0.00 d | 66.60 ± 0.07 e | |
| Acetobacter pomorum (SFT-21) | 100.31 ± 0.26 a | 99.29 ± 0.09 b | 93.59 ± 0.09 c | 100.48 ± 0.09 a | 89.84 ± 0.09 d | 92.57 ± 0.17 a | 77.72 ± 0.25 b | 76.67 ± 0.09 c | 71.83 ± 0.32 d | 68.04 ± 0.08 e | |
| Acetobacter pomorum (SFT-22) | 93.01 ± 0.21 d | 120.86 ± 0.07 a | 91.66 ± 0.14 e | 100.63 ± 0.14 b | 93.68 ± 0.27 c | 94.96 ± 0.06 a | 84.87 ± 0.11 b | 83.01 ± 0.06 c | 61.26 ± 0.12 d | 55.28 ± 0.23 e | |
| Acetobacter pomorum (SFT-24) | 102.28 ± 0.07 c | 114.51 ± 0.07 b | 123.88 ± 0.50 a | 98.20 ± 0.22 d | 80.68 ± 0.22 e | 95.70 ± 0.13 a | 87.10 ± 0.13 c | 87.42 ± 0.07 b | 57.80 ± 0.07 e | 65.39 ± 0.00 d | |
| Acetobacter pasteurianus (SFT-25) | 84.52 ± 0.07 e | 94.49 ± 0.15 b | 90.86 ± 0.43 c | 100.69 ± 0.07 a | 89.94 ± 0.08 d | 97.43 ± 0.46 a | 92.29 ± 0.08 d | 86.77 ± 0.08 e | 96.43 ± 0.54 b | 93.44 ± 0.23 c | |
| Gluconobacter oxydans (SFT-26) | 43.82 ± 0.23 e | 60.18 ± 0.11 d | 144.16 ± 0.23 b | 96.68 ± 0.12 c | 185.12 ± 0.35 a | 137.11 ± 0.19 c | 211.32 ± 0.19 a | 94.81 ± 0.56 e | 130.98 ± 0.19 d | 172.73 ± 0.56 b | |
| Gluconobacter oxydans (SFT-27) | 72.19 ± 0.13 e | 86.73 ± 0.25 d | 251.50 ± 0.37 a | 88.60 ± 0.25 c | 171.23 ± 0.25 b | 96.48 ± 0.12 d | 89.44 ± 0.24 e | 143.57 ± 0.00 c | 158.50 ± 0.25 a | 148.18 ± 0.36 b | |
| Acetobacter pomorum (SFT-28) | 109.16 ± 0.25 b | 102.64 ± 0.25 c | 116.01 ± 0.09 a | 98.79 ± 0.17 d | 93.19 ± 0.42 e | 103.35 ± 0.07 b | 110.05 ± 0.15 a | 101.33 ± 0.29 c | 69.72 ± 0.08 d | 66.33 ± 0.00 e | |
| Acetobacter ascendens (SFT-29) | 92.54 ± 0.41 e | 99.01 ± 0.08 c | 94.89 ± 0.08 d | 100.38 ± 0.09 b | 105.23 ± 0.09 a | 94.46 ± 0.15 a | 83.37 ± 0.07 b | 77.61 ± 0.15 d | 78.79 ± 0.08 c | 69.70 ± 0.22 e | |
| Acetobacter ascendens (SFT-30) | 95.06 ± 0.11 e | 101.59 ± 0.21 c | 106.45 ± 0.31 a | 99.51 ± 0.11 d | 103.97 ± 0.42 b | 96.04 ± 0.08 a | 88.12 ± 0.16 b | 74.21 ± 0.08 d | 77.33 ± 0.24 c | 70.37 ± 0.08 e | |
| Acetobacter ascendens (SFT-31) | 121.31 ± 0.25 c | 154.97 ± 0.12 a | 125.67 ± 0.12 b | 98.07 ± 0.24 d | 90.80 ± 0.49 e | 87.24 ± 0.09 c | 61.72 ± 0.19 e | 89.13 ± 0.28 b | 107.37 ± 0.10 a | 78.36 ± 0.10 d | |
| Acetobacter pomorum (SFT-32) | 156.12 ± 0.13 a | 122.40 ± 0.13 b | 102.64 ± 0.25 c | 99.80 ± 0.12 d | 93.75 ± 0.12 e | 153.29 ± 1.20 d | 259.88 ± 0.24 a | 212.69 ± 1.68 b | 139.64 ± 0.72 e | 159.28 ± 0.24 c | |
| Acetobacter malorum (SFT-33) | 117.70 ± 0.08 a | 89.90 ± 0.29 d | 75.35 ± 0.07 e | 101.86 ± 0.22 c | 117.34 ± 0.15 b | 72.20 ± 0.16 a | 16.59 ± 0.07 e | 23.63 ± 0.00 d | 43.03 ± 0.07 b | 29.98 ± 0.04 c | |
| Acetobacter malorum (SFT-36) | 176.67 ± 0.25 a | 125.85 ± 0.08 b | 82.67 ± 0.25 d | 101.30 ± 0.09 c | 55.66 ± 0.49 e | 80.09 ± 0.07 a | 40.28 ± 0.23 b | 23.66 ± 0.07 c | 17.47 ± 0.03 e | 19.66 ± 0.20 d | |
| Acetobacter malorum (SFT-37) | 100.68 ± 0.07 c | 118.63 ± 0.07 a | 105.50 ± 0.08 b | 99.59 ± 0.44 d | 64.57 ± 0.15 e | 78.76 ± 0.04 a | 36.27 ± 0.08 b | 19.86 ± 0.12 d | 30.14 ± 0.08 c | 36.3 ± 0.12 b | |
| Sample | pH | Titratable Acidity (%) | Microbial Count (logCFU/mL) | ||||||||||
|---|---|---|---|---|---|---|---|---|---|---|---|---|---|
| Day | 25 °C | 30 °C | 35 °C | 40 °C | 25 °C | 30 °C | 35 °C | 40 °C | 25 °C | 30 °C | 35 °C | 40 °C | |
| Acetobacter pasteurianus (SFT-3) | 0 | 6.14 ± 0.01 1,ns | 6.14 ± 0.00 | 6.12 ± 0.01 | 6.13 ± 0.02 | 0.10 ± 0.01 bc | 0.12 ± 0.00 a | 0.11 ± 0.01 ab | 0.09 ± 0.01 c | 6.13 ± 0.08 ns | 6.08 ± 0.15 | 6.22 ± 0.07 | 6.22 ± 0.07 |
| 1 | 5.18 ± 0.01 b | 4.94 ± 0.01 c | 4.61 ± 0.00 d | 5.67 ± 0.00 a | 0.14 ± 0.01 c | 0.21 ± 0.00 b | 0.34 ± 0.03 a | 0.10 ± 0.02 d | 6.40 ± 0.52 ns | 6.36 ± 0.67 | 6.53 ± 0.25 | 6.24 ± 0.49 | |
| 2 | 4.61 ± 0.01 b | 4.60 ± 0.01 b | 4.22 ± 0.01 c | 5.07 ± 0.00 a | 0.35 ± 0.01 b | 0.38 ± 0.03 b | 0.81 ± 0.03 a | 0.18 ± 0.00 c | 7.15 ± 0.45 b | 7.17 ± 0.42 b | 8.05 ± 0.67 a | 6.95 ± 0.07 b | |
| 3 | 4.35 ± 0.01 b | 4.32 ± 0.00 c | 3.97 ± 0.01 d | 4.50 ± 0.01 a | 0.57 ± 0.00 b | 0.60 ± 0.03 b | 1.32 ± 0.02 a | 0.41 ± 0.01 c | 8.81 ± 0.95 ns | 8.85 ± 0.77 | 8.92 ± 0.98 | 8.64 ± 0.81 | |
| Acetobacter pasteurianus (SFT-13) | 0 | 6.42 ± 0.00 a | 6.40 ± 0.01 b | 6.38 ± 0.01 c | 6.41 ± 0.00 ab | 0.09 ± 0.00 b | 0.10 ± 0.02 ab | 0.12 ± 0.01 a | 0.09 ± 0.01 b | 6.36 ± 0.08 c | 6.54 ± 0.04 b | 6.71 ± 0.02 a | 6.53 ± 0.03 b |
| 1 | 5.32 ± 0.01 a | 4.92 ± 0.00 b | 4.84 ± 0.01 c | 4.68 ± 0.00 d | 0.13 ± 0.01 d | 0.21 ± 0.01 c | 0.24 ± 0.01 b | 0.31 ± 0.01 a | 6.46 ± 0.34 c | 6.77 ± 0.19 bc | 6.92 ± 0.19 b | 7.42 ± 0.12 a | |
| 2 | 4.78 ± 0.01 a | 4.50 ± 0.00 b | 4.46 ± 0.01 c | 4.26 ± 0.00 d | 0.25 ± 0.01 d | 0.44 ± 0.00 c | 0.47 ± 0.02 b | 0.77 ± 0.02 a | 7.54 ± 0.34 ns | 8.18 ± 0.57 | 8.41 ± 0.66 | 8.58 ± 0.57 | |
| 3 | 4.50 ± 0.00 a | 4.24 ± 0.00 b | 4.11 ± 0.00 c | 4.00 ± 0.01 d | 0.42 ± 0.00 d | 0.71 ± 0.02 c | 0.92 ± 0.01 b | 1.29 ± 0.01 a | 8.70 ± 0.71 ns | 9.00 ± 0.75 | 9.05 ± 0.82 | 8.99 ± 0.86 | |
| Acetobacter pasteurianus (SFT-18) | 0 | 6.34 ± 0.00 b | 6.34 ± 0.01 b | 6.31 ± 0.02 c | 6.37 ± 0.01 a | 0.10 ± 0.01 b | 0.09 ± 0.01 b | 0.12 ± 0.01 a | 0.09 ± 0.00 b | 5.93 ± 0.13 ns | 5.93 ± 0.11 | 5.89 ± 0.10 | 6.01 ± 0.12 |
| 1 | 4.89 ± 0.01 a | 4.87 ± 0.01 b | 4.49 ± 0.01 c | 4.89 ± 0.01 a | 0.22 ± 0.01 b | 0.22 ± 0.01 b | 0.43 ± 0.02 a | 0.22 ± 0.01 b | 6.67 ± 0.02 bc | 6.75 ± 0.02 b | 6.98 ± 0.18 a | 6.54 ± 0.10 c | |
| 2 | 4.24 ± 0.01 c | 4.43 ± 0.00 b | 4.12 ± 0.01 d | 4.54 ± 0.00 a | 0.75 ± 0.01 b | 0.53 ± 0.02 c | 0.98 ± 0.01 a | 0.43 ± 0.00 d | 8.11 ± 0.64 ns | 7.76 ± 0.35 | 8.40 ± 0.50 | 7.43 ± 0.60 | |
| 3 | 3.93 ± 0.00 c | 4.10 ± 0.01 b | 3.85 ± 0.00 d | 4.31 ± 0.01 a | 1.35 ± 0.00 b | 0.95 ± 0.02 c | 1.68 ± 0.02 a | 0.66 ± 0.01 d | 9.42 ± 0.81 ns | 9.23 ± 0.76 | 9.52 ± 0.49 | 9.01 ± 0.72 | |
| Acetobacter ascendens (SFT-30) | 0 | 6.33 ± 0.01 ab | 6.31 ± 0.02 b | 6.33 ± 0.01 ab | 6.34 ± 0.01 a | 0.09 ± 0.02 ns | 0.09 ± 0.01 | 0.09 ± 0.01 | 0.11 ± 0.01 | 6.50 ± 0.03 c | 6.77 ± 0.04 a | 6.65 ± 0.02 b | 6.46 ± 0.06 c |
| 1 | 5.08 ± 0.00 b | 4.89 ± 0.02 d | 4.99 ± 0.00 c | 5.30 ± 0.01 a | 0.16 ± 0.02 b | 0.22 ± 0.01 a | 0.20 ± 0.01 a | 0.13 ± 0.01 c | 7.10 ± 0.23 b | 7.77 ± 0.02 a | 6.83 ± 0.07 c | 6.68 ± 0.15 c | |
| 2 | 4.59 ± 0.00 c | 4.52 ± 0.00 d | 4.72 ± 0.01 b | 4.87 ± 0.00 a | 0.37 ± 0.01 b | 0.42 ± 0.02 a | 0.31 ± 0.01 c | 0.24 ± 0.01 d | 8.05 ± 0.89 ns | 8.51 ± 0.58 b | 7.51 ± 0.68 | 7.34 ± 0.58 | |
| 3 | 4.31 ± 0.01 c | 4.26 ± 0.01 d | 4.49 ± 0.01 b | 4.55 ± 0.01 a | 0.63 ± 0.01 b | 0.68 ± 0.00 a | 0.44 ± 0.02 c | 0.41 ± 0.01 d | 9.10 ± 0.95 ns | 9.30 ± 1.19 | 8.99 ± 0.73 | 8.91 ± 0.66 | |
| Acetobacter ascendens (SFT-31) | 0 | 6.40 ± 0.01 ab | 6.38 ± 0.02 bc | 6.37 ± 0.01 c | 6.41 ± 0.01 a | 0.08 ± 0.00 b | 0.11 ± 0.00 a | 0.12 ± 0.01 a | 0.08 ± 0.01 b | 6.36 ± 0.06 b | 6.48 ± 0.06 ab | 6.55 ± 0.09 a | 6.37 ± 0.06 b |
| 1 | 5.75 ± 0.00 b | 5.30 ± 0.01 c | 4.88 ± 0.00 d | 5.89 ± 0.01 a | 0.11 ± 0.02 c | 0.15 ± 0.00 b | 0.21 ± 0.01 a | 0.09 ± 0.00 c | 6.82 ± 0.15 bc | 7.12 ± 0.08 ab | 7.41 ± 0.18 a | 6.39 ± 0.53 c | |
| 2 | 5.04 ± 0.01 b | 4.65 ± 0.00 c | 4.57 ± 0.01 d | 5.71 ± 0.00 a | 0.19 ± 0.02 b | 0.38 ± 0.02 a | 0.39 ± 0.01 a | 0.12 ± 0.02 c | 7.52 ± 0.60 ns | 8.19 ± 0.50 | 8.40 ± 0.63 | 7.36 ± 0.51 | |
| 3 | 4.37 ± 0.01 b | 4.35 ± 0.01 c | 4.34 ± 0.01 c | 5.46 ± 0.01 a | 0.58 ± 0.02 b | 0.61 ± 0.00 a | 0.61 ± 0.02 a | 0.14 ± 0.00 c | 8.37 ± 0.81 ns | 8.95 ± 0.75 | 8.90 ± 0.94 | 8.04 ± 0.58 | |
| Gluconobacter oxydans (SFT-26) | 0 | 6.68 ± 0.01 a | 6.67 ± 0.00 a | 6.64 ± 0.01 b | 6.67 ± 0.00 a | 0.09 ± 0.01 ns | 0.09 ± 0.01 | 0.10 ± 0.00 | 0.09 ± 0.01 | 6.11 ± 0.07 b | 6.20 ± 0.01 a | 6.27 ± 0.02 a | 6.23 ± 0.02 a |
| 1 | 5.06 ± 0.00 d | 5.24 ± 0.02 c | 5.76 ± 0.01 b | 6.12 ± 0.01 a | 0.13 ± 0.01 ns | 0.12 ± 0.02 | 0.11 ± 0.02 | 0.10 ± 0.01 | 7.51 ± 0.21 a | 6.94 ± 0.17 ab | 6.45 ± 0.38 b | 6.35 ± 0.76 b | |
| 2 | 4.31 ± 0.01 d | 4.33 ± 0.01 c | 4.65 ± 0.00 b | 6.02 ± 0.00 a | 0.24 ± 0.02 a | 0.24 ± 0.02 a | 0.18 ± 0.00 b | 0.10 ± 0.00 c | 8.37 ± 0.79 ns | 8.35 ± 0.83 | 8.09 ± 0.84 | 7.34 ± 0.58 | |
| 3 | 3.80 ± 0.01 c | 3.77 ± 0.00 d | 4.46 ± 0.00 b | 5.89 ± 0.00 a | 0.52 ± 0.02 a | 0.52 ± 0.00 a | 0.21 ± 0.00 b | 0.11 ± 0.00 c | 9.54 ± 0.68 ns | 9.41 ± 0.53 | 9.37 ± 0.53 | 8.48 ± 0.63 | |
| Gluconobacter oxydans (SFT-27) | 0 | 6.22 ± 0.01 a | 6.21 ± 0.00 ab | 6.20 ± 0.00 b | 6.21 ± 0.01 ab | 0.11 ± 0.00 ns | 0.11 ± 0.01 | 0.12 ± 0.01 | 0.11 ± 0.00 | 5.87 ± 0.46 ns | 5.97 ± 0.69 | 6.21 ± 0.30 | 6.11 ± 0.35 |
| 1 | 5.57 ± 0.01 b | 5.12 ± 0.01 d | 5.30 ± 0.00 c | 5.88 ± 0.00 a | 0.13 ± 0.01 a | 0.14 ± 0.01 a | 0.13 ± 0.00 a | 0.11 ± 0.01 b | 7.49 ± 0.29 ns | 7.28 ± 0.43 | 7.00 ± 0.47 | 6.89 ± 0.90 | |
| 2 | 4.68 ± 0.01 b | 3.84 ± 0.01 d | 3.90 ± 0.01 c | 5.83 ± 0.02 a | 0.16 ± 0.01 c | 0.45 ± 0.01 a | 0.38 ± 0.00 b | 0.11 ± 0.00 d | 7.86 ± 0.36 ns | 8.01 ± 0.60 | 8.04 ± 0.70 | 7.41 ± 0.61 | |
| 3 | 3.63 ± 0.00 b | 3.56 ± 0.02 c | 3.55 ± 0.00 c | 5.83 ± 0.01 a | 0.73 ± 0.00 c | 0.75 ± 0.02 b | 0.79 ± 0.00 a | 0.13 ± 0.00 d | 8.19 ± 0.71 ns | 8.44 ± 0.87 | 8.55 ± 0.76 | 8.09 ± 0.77 | |
Disclaimer/Publisher’s Note: The statements, opinions and data contained in all publications are solely those of the individual author(s) and contributor(s) and not of MDPI and/or the editor(s). MDPI and/or the editor(s) disclaim responsibility for any injury to people or property resulting from any ideas, methods, instructions or products referred to in the content. |
© 2023 by the authors. Licensee MDPI, Basel, Switzerland. This article is an open access article distributed under the terms and conditions of the Creative Commons Attribution (CC BY) license (https://creativecommons.org/licenses/by/4.0/).
Share and Cite
Lee, D.-H.; Kim, S.-H.; Lee, C.-Y.; Jo, H.-W.; Lee, W.-H.; Kim, E.-H.; Choi, B.-K.; Huh, C.-K. Screening of Acetic Acid Bacteria Isolated from Various Sources for Use in Kombucha Production. Fermentation 2024, 10, 18. https://doi.org/10.3390/fermentation10010018
Lee D-H, Kim S-H, Lee C-Y, Jo H-W, Lee W-H, Kim E-H, Choi B-K, Huh C-K. Screening of Acetic Acid Bacteria Isolated from Various Sources for Use in Kombucha Production. Fermentation. 2024; 10(1):18. https://doi.org/10.3390/fermentation10010018
Chicago/Turabian StyleLee, Dong-Hun, Su-Hwan Kim, Chae-Yun Lee, Hyeong-Woo Jo, Won-Hee Lee, Eun-Hye Kim, Byung-Kuk Choi, and Chang-Ki Huh. 2024. "Screening of Acetic Acid Bacteria Isolated from Various Sources for Use in Kombucha Production" Fermentation 10, no. 1: 18. https://doi.org/10.3390/fermentation10010018
APA StyleLee, D.-H., Kim, S.-H., Lee, C.-Y., Jo, H.-W., Lee, W.-H., Kim, E.-H., Choi, B.-K., & Huh, C.-K. (2024). Screening of Acetic Acid Bacteria Isolated from Various Sources for Use in Kombucha Production. Fermentation, 10(1), 18. https://doi.org/10.3390/fermentation10010018

